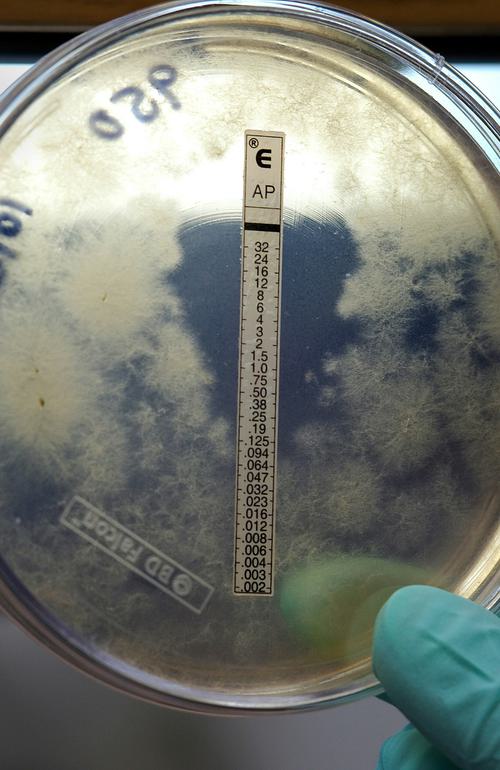

Testen Masterclass Bouwbiologie
Samen met bouwpartners testen wel regelmatig bouwmaterialen. Op deze pagina zullen we eigen testen of relevante testen van anderen delen. Zo hebben we in 2023 een test uitgevoerd met 17 verschillende isolatiematerialen.
Ken je interessante delen die het delen waard zijn of wil je samen met ons een test opzetten, neem dan contact met ons op.
Brandtest
Doel van deze brandtest was om te laten zien welke biobased isolatiematerialen er zijn en ook hoe ze zich gedragen bij brand. Daarnaast zijn ook vier synthetische en twee minerale isolaties getest. Uiteraard waren het geen geconditioneerde omstandigheden en je kunt er geen conclusies uit trekken! Maar wel mooi om te zien dat bijvoorbeeld cellulose bijna twee uur lang heeft volgehouden en in onze test alleen steenwol en kalkhennep beter waren. Ook inblaasstro deed het verrassend goed.